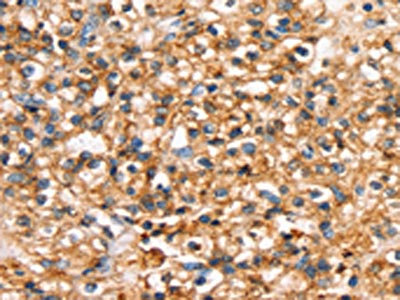

-
中文名稱:SLC34A3兔多克隆抗體
-
貨號:CSB-PA644639
-
規格:¥1100
-
圖片:
-
其他:
產品詳情
-
Uniprot No.:
-
基因名:SLC34A3
-
別名:HHRH antibody; Na(+) dependent phosphate cotransporter 2C antibody; Na(+) Pi cotransporter 2C antibody; Na(+)-dependent phosphate cotransporter 2C antibody; Na(+)/Pi cotransporter 2C antibody; NaPi 2c antibody; NaPi-2c antibody; NPT2C antibody; NPT2C_HUMAN antibody; NPTIIC antibody; SLC34A3 antibody; Sodium dependent phosphate transport protein 2C antibody; Sodium inorganic phosphate cotransporter IIC antibody; Sodium phosphate cotransporter 2C antibody; Sodium phosphate transport protein 2C antibody; Sodium-dependent phosphate transport protein 2C antibody; Sodium-phosphate transport protein 2C antibody; Sodium/inorganic phosphate cotransporter IIC antibody; Sodium/inorganic phosphate cotransporter; type IIC antibody; Sodium/phosphate cotransporter 2C antibody; solute carrier family 34 (sodium phosphate) member 3 antibody; solute carrier family 34 (sodium/phosphate contransporter); member 3 antibody; solute carrier family 34 (type II sodium/phosphate contransporter); member 3 antibody; Solute carrier family 34 member 3 antibody; type IIc Na+ Pi cotransporter antibody; Type IIc Na+/Pi cotransporter antibody
-
宿主:Rabbit
-
反應種屬:Human
-
免疫原:Synthetic peptide of Human SLC34A3
-
免疫原種屬:Homo sapiens (Human)
-
標記方式:Non-conjugated
-
抗體亞型:IgG
-
純化方式:Antigen affinity purification
-
濃度:It differs from different batches. Please contact us to confirm it.
-
保存緩沖液:-20°C, pH7.4 PBS, 0.05% NaN3, 40% Glycerol
-
產品提供形式:Liquid
-
應用范圍:ELISA,IHC
-
推薦稀釋比:
Application Recommended Dilution ELISA 1:1000-1:2000 IHC 1:25-1:100 -
Protocols:
-
儲存條件:Upon receipt, store at -20°C or -80°C. Avoid repeated freeze.
-
貨期:Basically, we can dispatch the products out in 1-3 working days after receiving your orders. Delivery time maybe differs from different purchasing way or location, please kindly consult your local distributors for specific delivery time.
-
用途:For Research Use Only. Not for use in diagnostic or therapeutic procedures.
相關產品
靶點詳情
-
功能:May be involved in actively transporting phosphate into cells via Na(+) cotransport in the renal brush border membrane. Probably mediates 20-30% of the apical influx.
-
基因功能參考文獻:
- genetic characteristics of 15 families with hereditary hypophosphatemia: Novel Mutations in PHEX and SLC34A3 PMID: 29505567
- This is the report of a patient with compound heterozygous mutations of SLC34A3 and normal skeletal features. Biallelic mutations in SLC34A3 can thus be associated with hypercalciuria not accompanied by rickets. PMID: 24924704
- Individuals with mutations affecting both SLC34A3 alleles had a significantly increased risk of kidney stone formation or medullary nephrocalcinosis, namely 46% compared with 6% observed in healthy family members carrying only the wild-type allele. PMID: 24700880
- this study reports the first cases of hereditary hypophosphatemic rickets with hypercalciuria in Africa and describes a novel causal mutation within the SLC34A3 gene PMID: 23246670
- A man with hereditary hypophosphataemic rickets with hypercalciuria & his 3 heterozygous children had a mutation in intron 5 of gene SLC34A3 (NM_080877.2:c[ 448 +5G>A] + [ 448 +5G>A]). PMID: 22806288
- Data show 101-bp deletion in intron 9 of the SLC34A3 gene. PMID: 22672866
- SLC34A3 mutations (exons and introns) were searched in two previously not reported hereditary hypophosphatemic rickets with hypercalciuria kindreds, which resulted in the identification of three novel mutations. PMID: 22387237
- these data suggest that mutations in SLC34A3 in hereditary hypophosphatemic rickets with hypercalciuria result in defective processing and stability PMID: 22159077
- Functionally important sites in the predicted first and fourth extracellular linkers of the type IIa Na+/Pi cotransporter (NaPi-IIa) were identified by cysteine scanning mutagenesis (Ehnes et al., 2004). PMID: 15504899
- NaP(i)-IIc has a key role in the regulation of phosphate homeostasis. PMID: 16358214
- Loss of function of the SLC34A3 protein presumably results in a primary renal tubular defect and is compatible with the hereditary hypophosphatemic rickets with hypercalciuria phenotype. PMID: 16358215
- Therefore, understanding the mechanisms that control the apical expression of NaPi-IIa and NaPi-IIc as well as their functional properties is critical to understanding how an organism achieves P i homeostasis. PMID: 16955105
- Hereditary hypophosphatemic rickets with hypercalciuria were speculated to be associated with the abnormal functions of phosphate transporter gene type IIc. PMID: 17968493
- A novel missense mutation in SLC34A3 causes hereditary hypophosphatemic rickets with hypercalciuria in humans. PMID: 18480181
- Novel mutation in the SLC34A3 gene in a patient with an unusual presentation of hereditary hypophosphatemic rickets with hypercalciuria. PMID: 19820004
顯示更多
收起更多
-
相關疾病:Hereditary hypophosphatemic rickets with hypercalciuria (HHRH)
-
亞細胞定位:Membrane; Multi-pass membrane protein.
-
蛋白家族:SLC34A transporter family
-
數據庫鏈接:
Most popular with customers
-
-
YWHAB Recombinant Monoclonal Antibody
Applications: ELISA, WB, IHC, IF, FC
Species Reactivity: Human, Mouse, Rat
-
Phospho-YAP1 (S127) Recombinant Monoclonal Antibody
Applications: ELISA, WB, IHC
Species Reactivity: Human
-
-
-
-
-